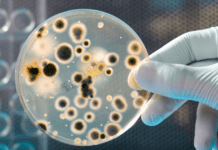
Elizabethkingia meningoseptica: Patógeno Oportunista de Alta Resistência resistência antimicrobiana

Na última sexta-feira, 12 de janeiro, a Agência Nacional de Vigilância Sanitária (Anvisa) informou a proibição da importação, comercialização e utilização de seis lotes da fórmula infantil em pó Nutramigen LGG no Brasil.
Essa decisão foi tomada de forma preventiva, em resposta a um alerta da Food and Drug Administration (FDA) dos Estados Unidos, que recomendou o recolhimento voluntário do produto devido ao risco de contaminação por uma bactéria capaz de desencadear episódios de meningite, podendo levar à morte.
Risco de contaminação em fórmula para bebês
Segundo a Resolução – RE Nº 100 (10 de janeiro de 2024), publicada no Diário Oficial da União, está proibida a comercialização, distribuição, importação e o uso de alguns lotes da fórmula infantil Nutramigen LGG – destinada a bebês com alergia ao leite de vaca.


A medida foi preventiva, considerando o comunicado emitido pela FDA sobre a fórmula, após ser informada sobre a possível contaminação desses lotes pela bactéria Cronobacter sakazakii. O patógeno é uma bactéria associada principalmente a infecções em recém-nascidos, prematuros, bebês com baixo peso e indivíduos imunossuprimidos.
A principal complicação relacionada à contaminação é a meningite. No entanto, a agência ressalta que também há relatos de casos de enterocolite necrosante, bacteremia, sepse e possíveis sequelas irreversíveis.
Até o momento, a fabricante Reckitt/Mead Johnson Nutrition afirmou que não foram identificadas infecções relacionadas ao consumo dos lotes proibidos.
Quais os lotes que foram proibidos?
Os lotes da fórmula infantil em pó Nutramigen LGG que foram proibidos são: ZL3FHG, ZL3FMH, ZL3FPE, ZL3FQD, ZL3FRW, ZL3FX, todos com validade até janeiro de 2025. Segundo a Anvisa, nenhum destes foi exportado para o Brasil.


Cronobacter sakazakii
Cronobacter sakazakii é uma bactéria que pode ser encontrada naturalmente no meio ambiente, podendo viver em alimentos secos, como fórmulas infantis em pó, leite em pó, chás de ervas e amidos.
As infecções em bebês geralmente ocorrem nos primeiros dias ou semanas de vida e, embora raras, podem ser fatais. É mais comum em bebês menores de 2 meses, prematuros, com baixo peso (< 2,5 kg) ou imunossuprimidos. Casos em crianças com mais de 1 ano são considerados raros.
Cerca de 2 a 4 casos são notificados ao CDC todos os anos, mas este número pode não refletir o verdadeiro número de doenças – visto que a maioria dos hospitais e laboratórios não são obrigados a comunicar as infecções por este patógeno aos departamentos de saúde.
A condição em bebês geralmente começa com febre e dificuldade de alimentação, choro excessivo e/ou falta de energia. Alguns bebês também podem ter convulsões, e frequentemente há quadros de meningite. Ainda, a bactéria é associada a surtos de sepse e enterocolite necrosante.


O diagnóstico é realizado por cultura utilizando sangue ou líquido cefalorraquidiano de pacientes com meningite ou sepse. Estudos de imagem cerebrais auxiliam na identificação de complicações, como abscessos cerebrais.
Na suspeita, os bebês devem ser imediatamente internados em unidade de terapia intensiva (UTI) para administração de antibióticos – escolhido com base nos testes de suscetibilidade antimicrobiana.
Leia também: Escore de Rodwell para risco de sepse neonatal: critérios, pontuações e interpretação.
—
Referências:
U.S. FOOD AND DRUG ADMINISTRATION. Reckitt/Mead Johnson Nutrition Voluntarily Recalls Select Batches of Nutramigen Hypoallergenic Infant Formula Powder Because of Possible Health Risk. December 31, 2023. Disponível em: https://www.fda.gov/safety/recalls-market-withdrawals-safety-alerts/reckittmead-johnson-nutrition-voluntarily-recalls-select-batches-nutramigen-hypoallergenic-infant
Centers for Disease Control and Prevention. CDC. Cronobacter. Disponível em: https://www.cdc.gov/cronobacter/index.html
Centers for Disease Control and Prevention. CDC. Cronobacter Infection and Infants. Disponível em: https://www.cdc.gov/cronobacter/infection-and-infants.html
Ministério da Saúde. Agência Nacional de Vigilância Sanitária – Anvisa. Anvisa proíbe lotes da fórmula infantil Nutramigen. 12 de janeiro de 2024. Disponível em: https://www.gov.br/anvisa/pt-br/assuntos/noticias-anvisa/2024/anvisa-proibe-lotes-da-formula-infantil-nutramigen
DIÁRIO OFICIAL DA UNIÃO. Ministério da Saúde/Agência Nacional de Vigilância Sanitária/4ª Diretoria/Gerência-Geral de Inspeção e Fiscalização Sanitária. RESOLUÇÃO-RE Nº 100, DE 10 DE JANEIRO DE 2024. Disponível em: https://www.in.gov.br/web/dou/-/resolucao-re-n-100-de-10-de-janeiro-de-2024-537029794